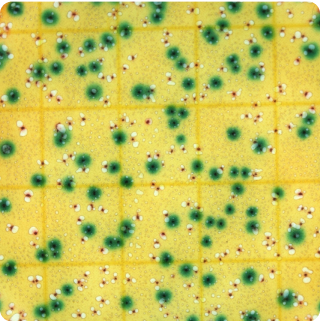
Total Coliforms & E. coli - Plate - 25g - Full Range

Total Coliforms & E. coli - Plate - 25g - Full Range
ECOLI
|
Turnaround Time:
2 - 4 days
|

Method Description
This comprehensive dual-detection method identifies both total coliforms and E. coli across all concentration ranges without predetermined limits, ensuring accurate results regardless of actual contamination levels. The full range approach is valuable when contamination levels are unknown or when investigating incidents that may involve very high bacterial counts. This testing provides maximum analytical flexibility while simultaneously assessing both general sanitation indicators and specific fecal contamination markers.
Analyte List
Technical Data Sheet
Method Name
Enumeration of Escherichia coli and Total Coliform in Foods and Dietary Supplements
Method Code
LAB-TM-059
Equipment Type
Culture Media - Plate
Equipment Details
3M Petrifilm (REC)
Method Reference
USP <62> - Vendor Modified, USP <2022> - Vendor Modified, USP <1223>, AOAC PTM 051801, AOAC OMA 2018.13
Reportable Unit
CFU/g, Swabs: CFU/Sw
Sample Size Requirements
5 g (extracts & isolates), all other: 100g
Available for
Food Products,
Dietary Supplements,
Botanicals (Raw Materials, Extracts, Finished Products),
Cannabis & Hemp (Plant Materials, Concentrates, MIP's, Beverages),
Coffee
Additional Information
Unavailable for
*Prices and offerings are subject to change without notice.